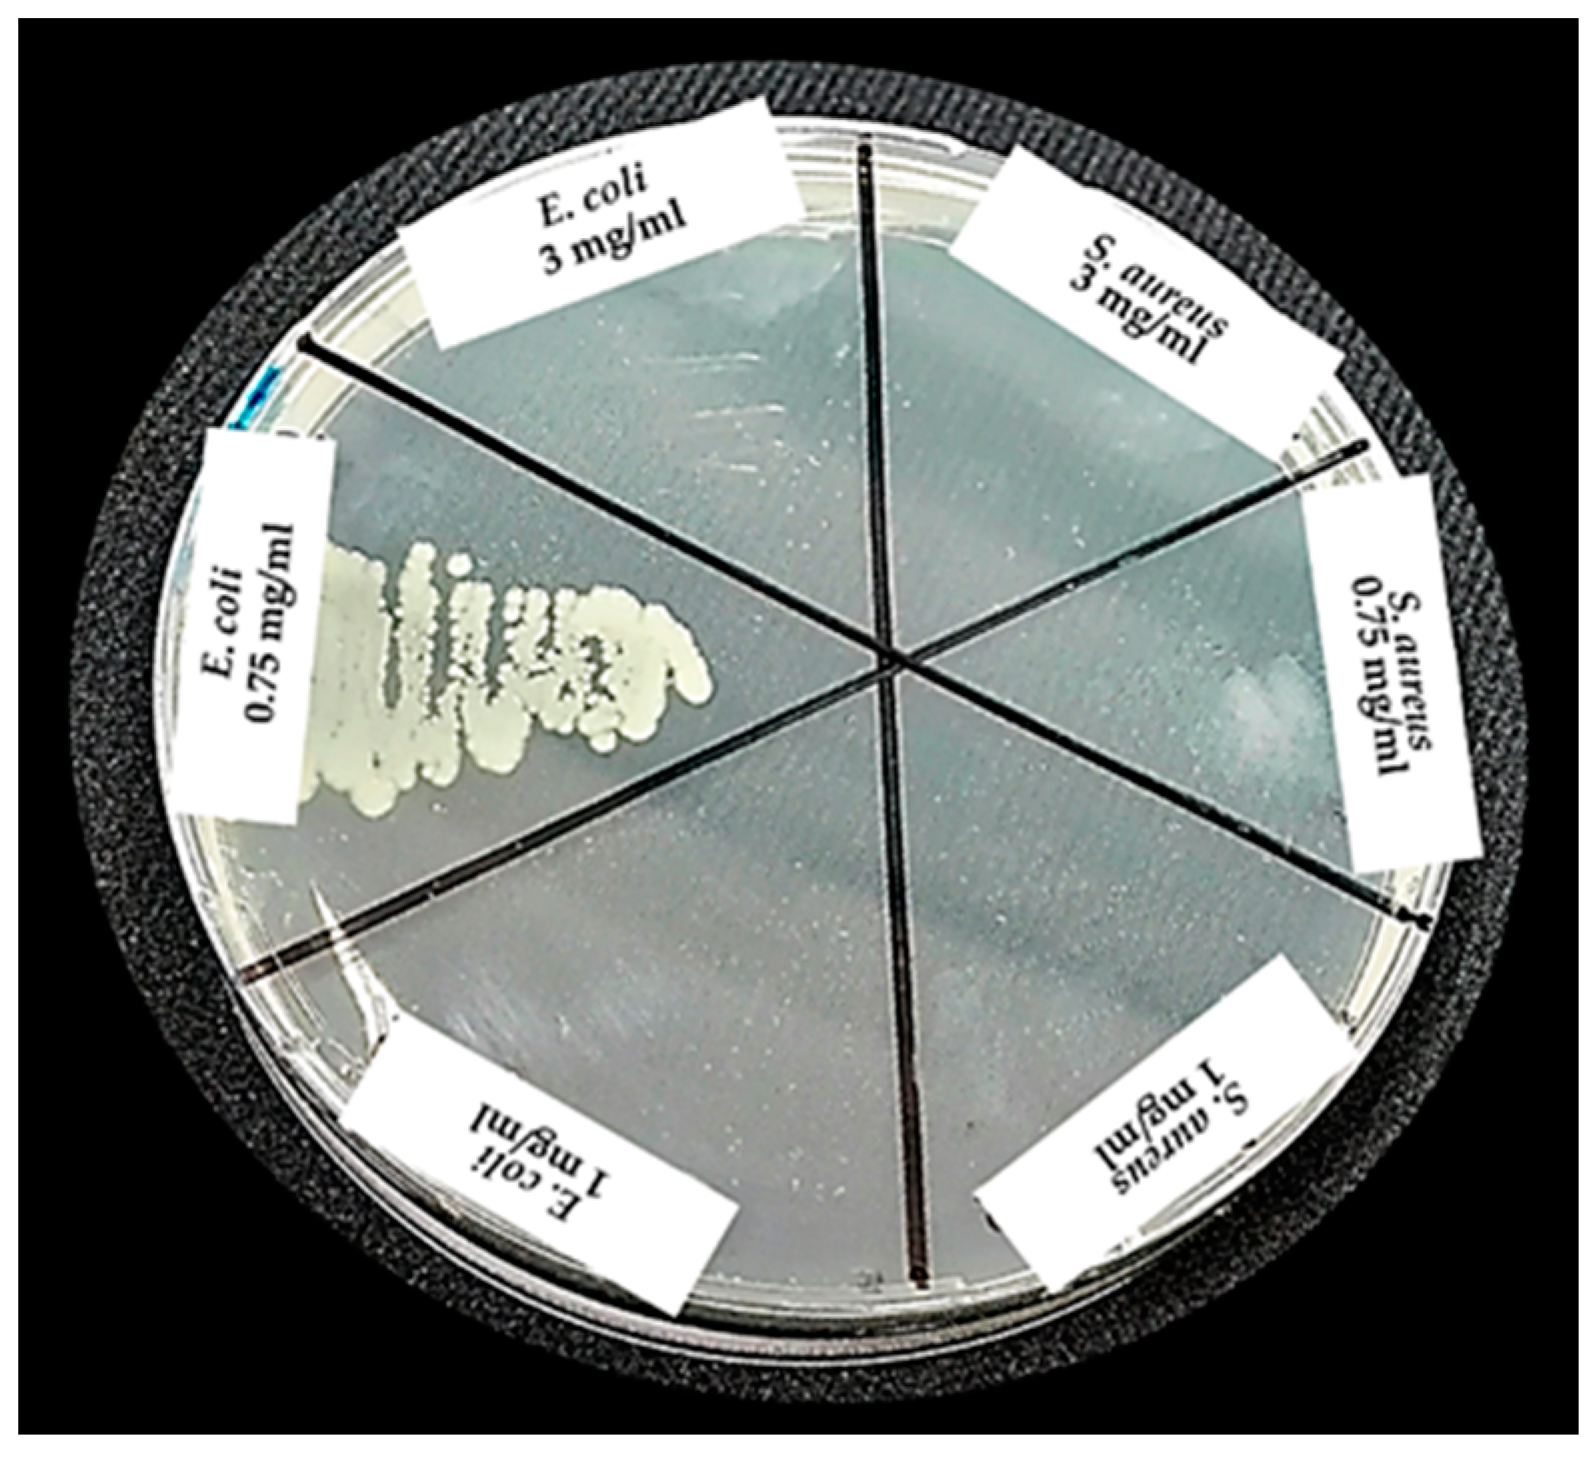
Materials 12 02202 g010 550

Obtaining Nanoparticles of Chilean Natural Zeolite and its Ion Exchange with Copper Salt (Cu2+) for Antibacterial Applications
Abstract
:1. Introduction
2. Materials and Methods
2.1. Materials
2.2. Obtaining Chilean Natural Nanozeolite, Reduction Processes
2.3. Ionic Exchange with Copper Salt to Nanozeolite
2.4. Characterization Methods for nZ, nZH, and nZH-Cu
2.5. Microbiological Assays
2.5.1. Disk Diffusion Assay
2.5.2. Determination of the Minimum Inhibitory Concentration and Minimum Bactericidal Concentration
2.5.3. Colony Count by the Micro Drop Technique
2.6. Statistical Analysis
3. Results and Discussion
3.1. Size Reduction of Natural Zeolite Samples
3.2. Morphological Characterization of nZ
3.3. Surface Area and Pore Size Distribution of Z, nZH, and nZH-Cu
3.4. EDX Analysis to nZ, nZH, and nZH-Cu
3.5. Analysis of Crystal States to nZ, nZH, and nZH-Cu
3.6. Physical Characterization of nZH and nZH-Cu using FTIR
3.7. Microbiological Assays
3.7.1. Disk Diffusion Assay
3.7.2. Determination of the MIC
3.7.3. Determination of MBC and Colony Count Using the Microdrop Technique
4. Conclusions
Author Contributions
Acknowledgments
Conflicts of Interest
References
- Callejas-Fernández, J.; Estelrich, J.; Quesada-Pérez, M.; Forcada, J. Soft Nanoparticles for Biomedical Applications, 1st ed.; The Royal Society of Chemistry: Cambridge, UK, 2014. [Google Scholar]
- Milenkovic, J.; Hrenovic, J.; Matijasevic, D.; Niksic, M.; Rajic, N. Bactericidal activity of Cu-, Zn-, and Ag-containing zeolites toward Escherichia coli isolates. Environ. Sci. Pollut. Res. 2017, 24, 20273–20281. [Google Scholar] [CrossRef] [PubMed]
- Gajardo, A.; Carrasco, R.; Mendoza, J.L. Yacimientos de Perlita, Zeolita, Bentonita y Granate para aplicacion medioambiental de las regiones VII y VIII, Chile Central-Sur. In Proceedings of the 10° Congreso Geológico Chileno 2003, Concepción, Chile, 6–10 October 2003; pp. 1–8. [Google Scholar]
- Sernageomin. Anuario de la Mineria de Chile 2015. In Proceedings of the Servicio Nacional de Geología y Minería, Santiago, Chile, 16 February 2015; pp. 1–253. [Google Scholar]
- García-Martínez, J.; Li, K. Mesoporous Zeolites. Preparation, Characterization and Applications, 1st ed.; Wiley-VCH: Weinheim, Germany, 2015. [Google Scholar]
- Mucsi, G.; Bohács, K. Wet gringing of zeolite in stirred media mill. IOP Conf. Ser. Mater. Sci. Eng. 2016, 123, 1–9. [Google Scholar] [CrossRef]
- Agion Features of Agion® Antimicrobial. Available online: http://www.sciessent.com/agion-antimicrobial-technology (accessed on 6 April 2017).
- Brody, A.; Strupinsky, E.; Kline, L. Active Packaging for Food Applications, 1st ed.; CRC Press: Boca Raton, FL, USA, 2001. [Google Scholar]
- Rieger, K.A.; Cho, H.J.; Yeung, H.F.; Fan, W.; Schiffman, J.D. Antimicrobial Activity of Silver Ions Released from Zeolites Immobilized on Cellulose Nanofiber Mats. ACS Appl. Mater. Interfaces 2016, 8, 3032–3040. [Google Scholar] [CrossRef] [PubMed]
- Álvarez-Paino, M.; Muñoz-Bonilla, A.; Fernández-García, M. Antimicrobial Polymers in the Nano-World. Nanomaterials 2017, 7, 48. [Google Scholar] [CrossRef] [PubMed]
- Zhou, Y.; Xia, M.; Ye, Y.; Hu, C. Antimicrobial ability of Cu2+-montmorillonite. Appl. Clay Sci. 2004, 27, 215–218. [Google Scholar] [CrossRef]
- Tekin, R.; Bac, N. Antimicrobial behavior of ion-exchanged zeolite X containing fragrance. Microporous Mesoporous Mater. 2016, 234, 55–60. [Google Scholar] [CrossRef]
- Alswat, A.A.; Ahmad, M.B.; Hussein, M.Z.; Ibrahim, N.A.; Saleh, T.A. Copper oxide nanoparticles-loaded zeolite and its characteristics and antibacterial activities. J. Mater. Sci. Technol. 2017, 33, 889–896. [Google Scholar] [CrossRef]
- Sani, R.K.; Peyton, B.M.; Brown, L.T. Copper-Induced Inhibition of Growth of Desulfovibrio desulfuricans G20: Assessment of Its Toxicity and Correlation with Those of Zinc and Lead. Appl. Environ. Microbiol. 2001, 67, 4765–4772. [Google Scholar] [CrossRef]
- Hostynek, J.J.; Maibach, H.I. Copper Hypersensitivity: Dermatologie Aspects. Dermatol. Ther. 2004, 17, 328–333. [Google Scholar] [CrossRef]
- Febré, N.; Viviana, S.; Báez, A.; Palza, H.; Delgado, K.; Aburto, I.; Silva, V. Comportamiento antibacteriano de partículas de cobre frente a microorganismos obtenidos de úlceras crónicas infectadas y su relación con la resistencia a antimicrobianos de uso común. Rev. Med. Chile 2016, 144, 1523–1530. [Google Scholar] [CrossRef]
- Slavin, Y.N.; Asnis, J.; Häfeli, U.O.; Bach, H. Metal nanoparticles: Understanding the mechanisms behind antibacterial activity. J. Nanobiotechnol. 2017, 15, 1–20. [Google Scholar] [CrossRef] [PubMed]
- Vázquez-Olmos, A.; Vega-Jiménez, A.; Paz-Díaz, B. Mecanosíntesis y efecto antimicrobiano de óxidos metálicos nanoestructurados. Mundo Nano. Rev. Interdiscip. Nanocienc. Nanotecnol. 2018, 11, 29–44. [Google Scholar] [CrossRef]
- Borkow, G.; Zatcoff, R.C.; Gabbay, J. Reducing the risk of skin pathologies in diabetics by using copper impregnated socks. Med. Hypotheses 2009, 73, 883–886. [Google Scholar] [CrossRef] [PubMed]
- Rácz, Á. Reduction of Surface Roughness and Rounding of Limestone Particles in a Stirred Media Mill. Chem. Eng. Technol. 2014, 37, 865–872. [Google Scholar] [CrossRef]
- Ozkan, A.; Yekeler, M.; Calkaya, M. Kinetics of fine wet grinding of zeolite in a steel ball mill in comparison to dry grinding. Int. J. Miner. Process. 2009, 90, 67–73. [Google Scholar] [CrossRef]
- Kong, C.; Tsuru, T. Zeolite nanocrystals prepared from zeolite microparticles by a centrifugation-assisted grinding method. Chem. Eng. Process. Process Intensif. 2010, 49, 809–814. [Google Scholar] [CrossRef]
- Rosa-Sibakov, N.; Sibakov, J.; Lahtinen, P.; Poutanen, K. Wet grinding and microfluidization of wheat bran preparations: Improvement of dispersion stability by structural disintegration. J. Cereal Sci. 2015, 64, 1–10. [Google Scholar] [CrossRef]
- Valdés, H.; Alejandro, S.; Zaror, C.A. Natural zeolite reactivity towards ozone: The role of compensating cations. J. Hazard. Mater. 2012, 227–228, 34–40. [Google Scholar] [CrossRef]
- Poblete Olivares, E.A. Pirólisis Catalítica de Desechos Plásticos Mediante Zeolitas Modificadas con Cobre; Ingeniería Civil Química, Universidad de Chile: Santiago, Chile, 2013. [Google Scholar]
- CLSI. M100 Performance Standards for Antimicrobial Susceptibility Testing; CLSI: Wayne, PA, USA, 2017. [Google Scholar]
- Cavalieri, S.J.; Harbeck, R.J.; McCarter, Y.S.; Ortez, J.H.; Rankin, I.D.; Sautter, R.L.; Sharp, S.E.; Spiegel, C.A. Manual de Pruebas de Susceptibilidad Antimicrobiana, 1st ed.; Library of Congress Cataloging in Publication Data: Seattle, WA, USA, 2005. [Google Scholar]
- Pérez, J.; Isaza, G.; Acosta, S. Actividad antibacteriana de extractos de Phenax rugosus y Tabebuia chrysantha. Biosalud 2007, 6, 59–68. [Google Scholar]
- Reyes-Jurado, F.; Palou, E.; López-Malo, A. Métodos de evaluación de la actividad antimicrobiana y de determinación de los componentes químicos de los aceite esenciales. Temas Sel. Ing. Aliment. 2014, 8, 68–78. [Google Scholar]
- Muñoz-Rojas, J.; Morales-García, Y.; Baez, A.; Quintero-Hernandez, V. Métodos económicos para la cuantificación de microorganismos. In Instituciones de Educación Superior la Labor Investigadora e Innovadora en México; Science Associated Editors: Cheyenne, WY, USA, 2016; pp. 67–84. [Google Scholar]
- Li, M.; Zhang, C.; Yang, X.-L.; Xu, H.-B. Microfluidization-assisted synthesis of hollow mesoporous silica nanoparticles. J. Sol-Gel Sci. Technol. 2013, 67, 501–506. [Google Scholar] [CrossRef]
- Evangelista, V.; Hernández, M.; Portillo, R. Tratamiento químico de clinoptilolita natural para la adsorción de gases contaminantes de bajo peso molecular. Available online: https://www.researchgate.net/publication/228790466_tratamiento_quimico_de_clinoptilolita_natural_para_la_adsorcion_de_gases_contaminantes_de_bajo_peso_molecular (accessed on 10 October 2018).
- Baghbanian, S.M.; Yadollahy, H.; Tajbakhsh, M.; Farhang, M.; Biparva, P. Palladium nanoparticles supported on natural nanozeolite clinoptilolite as a catalyst for ligand and copper-free C-C and C-O cross coupling reactions in aqueous medium. RSC Adv. 2014, 4, 62532–62543. [Google Scholar] [CrossRef]
- Alejandro, S.; Valdés, H.; Manero, M.H.; Zaror, C.A. BTX abatement using Chilean natural zeolite: The role of Bronsted acid sites. Water Sci. Technol. 2011, 66, 1759–1765. [Google Scholar] [CrossRef] [PubMed]
- Shankar, S.; Teng, X.; Rhim, J.W. Properties and characterization of agar/CuNP bionanocomposite films prepared with different copper salts and reducing agents. Carbohydr. Polym. 2014, 114, 484–492. [Google Scholar] [CrossRef] [PubMed]
- Formas, M. Identificación de Zeolitas Minera Formas. In Proceedings of the Identificación Zeolitas, Santiago, Chile, 10 September 2004; pp. 1–10. [Google Scholar]
- Feijoó, I.; Cabeza, M.; Merino, P.; Pena, G.; Pérez, M.C.; Cruz, S.; Rey, P. Evaluación del tamaño de cristalito y la micro-deformación durante el proceso de molienda mecánica del material compuesto AA6005A + 10% nano-TiC. Mater. Compuestos 2017, 2, 117–121. [Google Scholar]
- Céspedes-Ortiz, M.; Rodríguez-Iznaga, L.; Petranovskii, V.; Rizo-Beyra, R.; Aguilera-Domíngez, L. Zeolitas naturales de diferentes yacimientos cubanos: Composicición y estabilidad química y térmica. Rev. Cuba. Quím. 2011, 23, 80–88. [Google Scholar]
- Delmás, D.; Muñoz, P.; Lizardo, J. Síntesis de ZSM-5 para uso catalítico y caracterización por DRX y FTIR. Rev. Peru. Quím. Ing. Quím. 2009, 12, 49–53. [Google Scholar]
- Shoja Razavi, R.; Loghman-Estarki, M.R. Synthesis and Characterizations of Copper Oxide Nanoparticles Within Zeolite Y. J. Clust. Sci. 2012, 23, 1097–1106. [Google Scholar] [CrossRef]
- Liu, Y.; Ren, W.; Cui, H. Large-scale synthesis of paratacamite nanoparticles with controlled size and morphology. Micro Nano Lett. 2011, 6, 823. [Google Scholar] [CrossRef]
- Fu, L.-H.; Gao, Q.-L.; Ma, M.-G.; Qi, C.; Li, J.-F. Microwave-Hydrothermal Rapid Synthesis of Cellulose/Ag Nanocomposites and Their Antibacterial Activity. Nanomaterials 2018, 8, 978. [Google Scholar] [CrossRef]

| Sample | SBET (m2/g) | BJH Adsorp Average Pore Diameter (nm) | BJH Desorp Average Pore Diameter (nm) | Volume of Micropores (cm3/g) |
|---|---|---|---|---|
| nZ | 40.2 | 14.60 | 15.73 | 0.0050 |
| nZH | 181.5 | 9.00 | 11.62 | 0.0506 |
| nZH-Cu | 41.5 | 11.15 | 11.39 | 0.0050 |
| Microbial Strain | nZH-Cu (mg/mL) | Halo (mm) | Classification |
|---|---|---|---|
| E. coli | 1 | 20.2 ± 0.8 * | Intermediate |
| 3 | 23.2 ± 1.2 * | Susceptible | |
| S. aureus | 1 | 23.0 ± 1.1 ** | Susceptible |
| 3 | 24.7 ± 3.6 ** | Susceptible |
| Microbial Strain | E. coli | S. aureus | ||
|---|---|---|---|---|
| nZH-Cu (mg/mL) | 1 | 3 | 1 | 3 |
| Mean | 20.2 | 23.2 | 23 | 24.7 |
| Variance | 0.3 | 1.3 | 0.8 | 14.1 |
| Observations | 3 | 3 | 3 | 3 |
| Pearson’s correlation coefficient | –1 | 0.04 | ||
| Hypothetical difference of the means | 0 | 0 | ||
| Degrees of freedom | 2 | 2 | ||
| Statistic t | −3 | −0.76 | ||
| P (T <= t) a tail | 0.05 | 0.26 | ||
| Critical value of t (one tail) | 2.92 | 2.92 | ||
| P (T <= t) two tails | 0.10 | 0.53 | ||
| Critical value of t (two tails) | 4.30 | 4.30 | ||
| Microbial Strain | Serial Double Dilution of Inoculated Broth and nZH-Cu (mg/mL) | MIC (mg/mL) | MBC (mg/mL) | Count (Log10 CFU/mL) |
|---|---|---|---|---|
| E. coli | 3 | No turbidity | Without bacterial growth | Without bacterial growth |
| 1.5 | No turbidity | Not rehearsed | Without bacterial growth | |
| 0.75 | Turbidity | Bacterial growth | 6.57 ± 0.05 | |
| 0.375 | Turbidity | Not rehearsed | Not rehearsed | |
| 1 * | No turbidity a | Without bacterial growth b | Without bacterial growth | |
| S. aureus | 3 | No turbidity | Without bacterial growth | Without bacterial growth |
| 1.5 | No turbidity | Not rehearsed | Without bacterial growth | |
| 0.75 | No turbidity a | Without bacterial growth b | Without bacterial growth | |
| 0.375 | Turbidity | Not rehearsed | Not rehearsed | |
| 1 * | No turbidity | Without bacterial growth | Without bacterial growth |
© 2019 by the authors. Licensee MDPI, Basel, Switzerland. This article is an open access article distributed under the terms and conditions of the Creative Commons Attribution (CC BY) license (http://creativecommons.org/licenses/by/4.0/).
Share and Cite
Vergara-Figueroa, J.; Alejandro-Martín, S.; Pesenti, H.; Cerda, F.; Fernández-Pérez, A.; Gacitúa, W. Obtaining Nanoparticles of Chilean Natural Zeolite and its Ion Exchange with Copper Salt (Cu2+) for Antibacterial Applications. Materials 2019, 12, 2202. https://doi.org/10.3390/ma12132202
Vergara-Figueroa J, Alejandro-Martín S, Pesenti H, Cerda F, Fernández-Pérez A, Gacitúa W. Obtaining Nanoparticles of Chilean Natural Zeolite and its Ion Exchange with Copper Salt (Cu2+) for Antibacterial Applications. Materials. 2019; 12(13):2202. https://doi.org/10.3390/ma12132202
Chicago/Turabian StyleVergara-Figueroa, Judith, Serguei Alejandro-Martín, Héctor Pesenti, Fabiola Cerda, Arturo Fernández-Pérez, and William Gacitúa. 2019. "Obtaining Nanoparticles of Chilean Natural Zeolite and its Ion Exchange with Copper Salt (Cu2+) for Antibacterial Applications" Materials 12, no. 13: 2202. https://doi.org/10.3390/ma12132202
APA StyleVergara-Figueroa, J., Alejandro-Martín, S., Pesenti, H., Cerda, F., Fernández-Pérez, A., & Gacitúa, W. (2019). Obtaining Nanoparticles of Chilean Natural Zeolite and its Ion Exchange with Copper Salt (Cu2+) for Antibacterial Applications. Materials, 12(13), 2202. https://doi.org/10.3390/ma12132202

